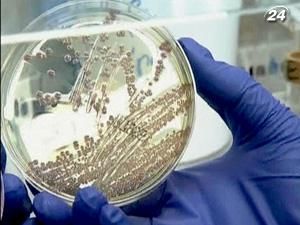
Источником кишечной инфекция могла быть пророщенная соя Источником кишечной инфекция могла быть пророщенная соя

О результатах первых лабораторных исследований бобовых сообщил министр сельского хозяйства земли Нижняя Саксония Герт Линдеманн.
"Очевидно, что местные климатические условия - подходят для выращивания бобовых, к сожалению, также они подходят для размножения бактерий", - сказал министр сельского хозяйства Нижней Саксонии Герт Линдеманн.
Ферму, на которой выращивали смертоносную сою, временно закрыли, всю продукцию изъяли из ресторанов и магазинов. От вспышки новой кишечной инфекции умерли уже 22 человека, заболели более 2 тысяч человек. Большинство случаев болезни зарегистрировали в Германии. Также Еscherichia coli обнаружили еще в около 10 странах Европы.